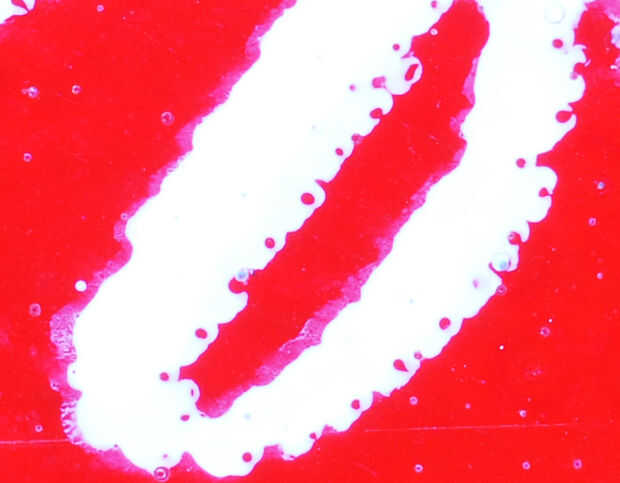

Paso 4: Diferencia en la ampliación

Se trata de demostrar cómo puede usar diferentes combinaciones de equipos para lograr diferentes niveles de ampliación, aquí hay algunas fotos para demostrar.
- Tomado con 55 m m Micro-Nikkor f1:2.8 sin tubos de extensión, fuelle o ringlight, (no una relación de reproducción 1:1)
- Tomado con 55 m m Micro-Nikkor f1:2.8 con 2 tubos de extensión Nikon PK-13 y ringlight Sunpak flash
- Toma con 55 m m Micro-Nikkor f1:2.8 con tubo de extensión Nikon PK-13, fuelle Nikon PB-6 (extensión completa) y ringlight Sunpak flash.
Como se puede ver, cuanto más la lente es sensor de la imagen (cámara), mayor será el aumento.
El fucsia que veis es donde las tintas han desangrado juntos. Los puntos en rojo son las burbujas de aire en la tinta durante la impresión.